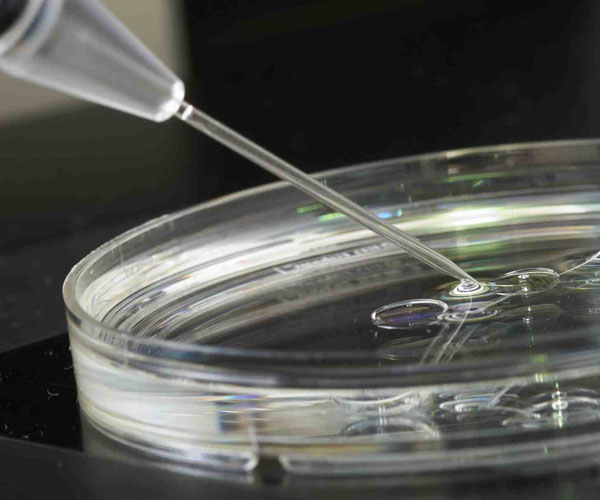

Ο Γέροντας Εφραίμ Φιλοθεΐτης μιλάει για την απέραντη φιλανθρωπία και μακροθυμία του Θεού. %audio%

Ο Γέροντας Εφραίμ Φιλοθεΐτης μιλάει για την απέραντη φιλανθρωπία και μακροθυμία του Θεού. %audio%

Ο Γεώργιος Ιλανίδης γεννήθηκε το έτος 1919 στην Κιουτάχεια της Μικράς Ασίας. Από τους πιστούς γονείς του, και ιδιαίτερα από την ευλαβέστατη μητέρα του Δέσποινα, πρωτοδιδάχθηκε την βαθειά πίστη στον Θεό και την απόλυτη εμπιστοσύνη στην πρόνοια Του. Ήταν μέν αγράμματη η μητέρα του, αλλά ήταν πολύ καλή νοικοκυρά και μεγάλωνε με αγάπη, με σωστή ανατροφή τα τέσσερα παιδιά της. Κάθε βράδυ τα συγκέντρωνε κοντά της για να προσευχηθούν όλοι μαζί και να κάνουν μετάνοιες. Τα συμβούλευε: «Πάντα να προσεύχεσθε και να κάνετε μετάνοιες για τ' αφεντικά σας, για να τα έχη ο Θεός καλά, να πηγαίνουν καλά οι δουλειές τους· έτσι θα είστε και σεις καλά και θα έχετε δουλειά». Από την μητέρα του ο Γιώργος έμαθε να προσεύχεται και ...

Ο Απόστολος Τίτος κατήγετο από το γένος του Μίνωα βασιλιά της Κρήτης καθώς λέγει Ζηνάς ο νομικός, ο συγγραφέας του βίου του αποστόλου, και τον οποίον αναφέρει ο Απόστολος Παύλος στην προς Τίτον επιστολήν του λέγοντας: «Ζηνάν τον νομικόν σπουδαίως πρόπεμψον» (Τίτ. 3,13). Αυτός, λοιπόν, ο θεσπέσιος Τίτος από νεαρή ηλικία έδειξε πολλή σπουδή και επιμέλεια στην παιδεία και μάθηση, που θαύμαζαν οι Έλληνες. Όταν έφτασε στην ηλικία των είκοσι ετών άκουσε άνωθεν θεϊκή φωνή, που του έλεγε: «Τίτε, πρέπει να αναχωρήσεις από εδώ για να σώσεις τη ψυχή σου, επειδή η εξωτερική αυτή παιδεία ουδόλως σε ωφελεί». Επειδή αυτή τη φωνή την θεώρησε ως φωνή των ειδώλων και των δαιμόνων και για να βεβαιωθεί περισσότερο ότι ήταν φωνή του Θεού ...
Οι κοινές προτεσταντικές θεολογικές απόψεις και το κοινό προτεσταντικό ήθος έχουν ως συνέπεια ν’ αξιολογούνται στο χώρο της Προτεσταντικής Εκκλησίας οι τεχνικές της παρεμβατικής γονιμοποίησης με βάση κάποιες κοινές θεολογικές απόψεις και ηθικές αξίες. Σ’ αυτές ανήκουν: Η βασική προτεσταντική άποψη ότι ο Θεός κυριαρχεί και ελέγχει την ασθένεια κι εργάζεται μέσα από την ανθρώπινη εφευρετικότητα και τεχνολογία για να τη θεραπεύσει και ν’ απαλύνει τον ανθρώπινο πόνο, γι’ αυτό οι πιστοί που δεν μπορούν να γνωρίζουν τη σημασία και το σκοπό της ασθένειας θα πρέπει να εμπιστεύονται την καλοσύνη και την πιστότητα του Θεού. Η θεολογική άποψη για την αξία της ανθρώπινης ελευθερίας από την οποία πηγάζει ο σεβασμός του προσώπου και η αυτονομία του, η οποία εκφράζεται πλήρως όταν υπάρχει ...

Η διδαχική προσφορά του Αγίου Κοσμά, διά του Ευαγγελικού κηρύγματος του, ήταν αποφασιστική για την χώρα μας και κυρίως στις περιοχές που είχαν κινδυνέψει από τον εκούσιο εξισλαμισμό. Οι εγκαταλελειμμένοι στην αμάθειά τους Έλληνες έπρεπε να διδαχθούν την πίστι τους. Η απλή και σε λαϊκή γλώσσα διδαχή του Αγίου συνάρπαζε τα πλήθη, που κατά χιλιάδες τον ακολουθούσαν και με δίψα πρόσμεναν να ακούσουν τα κηρύγματά του. Ο πρώτος βιογράφος του Όσιος Νικόδημος ο Αγιορείτης σημειώνει ότι «η διδαχή του ήταν καθώς ημείς αυτήκοοι αυτής εγενόμεθα, απλουστάτη, ωσάν εκείνη των αλιέων (δηλαδή των Αγίων Αποστόλων). Ήταν γαλήνιος και ησύχιος, όπου εφαίνετο καθολικά να είναι γεμάτη από χάριν του ιλαρού και ησυχίου Αγίου Πνεύματος». Ο αποστολικός νους του Αγίου εφρόντισε να εκπαιδεύση Ιεροκήρυκες. Εκτός ...

Και αυτό έχει το ακόλουθο αποτέλεσμα: Σε μια Ευρώπη η οποία υφίσταται την μεγαλύτερη μεταμόρφωση της από τον Δεύτερο Παγκόσμιο Πόλεμο και με μεγαλύτερη παγκόσμια αποσταθεροποίηση να προβάλλει στον ορίζοντα, οι κοινότητες πιστών ενδέχεται να θυματοποιούνται όλο και περισσότερο τα επόμενα δέκα με είκοσι χρόνια. Κάποιοι γίνονται εύκολα αποδιοπομπαίοι τράγοι στο βωμό της πολιτικής σκοπιμότητας και δημαγωγίας. Ενώ η Ευρώπη και οι Ηνωμένες Πολιτείες διέρχονται τη χειρότερη οικονομική κρίση από τη καταστροφή της Γουόλ Στριτ το 1929, υπάρχουν ακόμα ομάδες και στις δύο ηπείρους, ειδικά από την πλευρά της ακροδεξιάς, που προσπαθούν να στοχοποιήσουν κάποιες ομάδες. Ωστόσο αυτό δεν είναι μόνο η ενασχόληση της ακροδεξιάς. Και η ακροδεξιά με την προσκόλλησή της στην αναρχία και τη βίαιη πολιτική αλλαγή θεωρεί ...

Ολοκληρώθηκαν οι εορταστικές εκδηλώσεις για την μνήμη του Αγίου Κοσμά του Αιτωλού στην Ιερά Μητρόπολη Ιερισού, Αγίου Όρους και Αρδαμερίου με αφορμή τα 300 χρόνια από την γέννηση του Εθναποστόλου και Ισαποστόλου Κοσμά του Αιτωλού. Το πρόγραμμα των εκδηλώσεων έλαβε χώρα στην Ιερά Μονή Αγίου Κοσμά του Αιτωλού Αρναίας παρουσία του Μητροπολίτου Ιερισσού Αρδαμερίου και Αγίου όρους κ Θεοκλήτου, κληρικών και λαικών. Κεντρικοί ομιλητές της εκδήλωσης ήταν η καθηγήτρια της Φιλοσοφικής Σχολής Αθηνών Μαρία Μαντούβαλου η οποία ανέπτυξε το θέμα: «Η αναγκαιότητα της παρουσίας του Αγίου Κοσμά σήμερα» και ο Αρχιμ. Χρυσόστομος Μαιδώνης, Πρωτοσύγκελος της Ιεράς Μητροπόλεως Ιερισσού, ο οποίος μίλησε με θέμα:« Η προάσπιση της αργίας της Κυριακής, η αιτία του μαρτυρίου του Αγίου Κοσμά». Το Συμπόσιο έτυχε της μέριμνας και ...

Συνεχίζοντας στη δημοσίευση της μελέτης του Δρ Αθανασίου Κολιοφούτη για την ποιμαντική προσέγγιση των ατόμων που πάσχουν από διαταραχή αυτισμού και των οικογενειών τους παρακο-λουθούμε την ανάπτυξη περαιτέρω ποιμαντικών προτάσεων για τις δυνατές δράσεις που μπορούν ν' αναπτυχθούν. Η πρόσκληση σχετικών επιστημόνων για την επαρκή ενημέρωση των ανθρώπων αυτών σχετικά με τον δέοντα τρόπο αντιμετώπισης των συνεπειών της αυτιστικής διαταραχής η η διοργάνωση κύκλων βιωματικών σεμιναρίων στα πλαίσια της ενορίας, για την εμπέδωση πρακτικών τρόπων αντιμετώπισης καθημερινών προβλημάτων από τους γονείς αυτών των παιδιών, θα αποδείξει ενώπιόν του ποιμνίου ότι η ποιμαντική συμβουλευτική δεν αφίσταται την επιστημονικής προσέγγισης του προβλήματος. Η κατά διαστήματα παρουσία του ίδιου του επισκόπου στους ενοριακούς κύκλους παρουσίας αυτών των ανθρώπων, θα τους κάνει να αισθανθούν ότι βρίσκονται συνεχώς ...

Κατά την πολύχρονη θητεία μου στη Δασική Υπηρεσία, από το 1973 σε συζητήσεις μεταξύ των υπαλλήλων και εργαζομένων της Δασικής Υπηρεσίας εκφράζονταν άλλοτε ως επιθυμία, άλλοτε ως παράπονο, αλλά και ως ευχή και προσευχή συνάμα, πως πρέπει η Δασική Υπηρεσία και οι υπάλληλοι της να αποκτήσουν προστάτη Άγιο, όπως έχουν τόσα Επαγγέλματα, Κλάδοι και Υπηρεσίες. Οι υπάλληλοι του Δασαρχείου Αρναίας, με τη θεμελίωση της Ιερά Μονής του Αγίου Κοσμά του Αιτωλού, το 2001, στις καταπράσινες πλαγιές του Χολομώντα, αισθανθήκαμε συνδεδεμένοι με τον Άγιο, που, κοντά στα τόσα άλλα, κήρυξε την αγάπη για τα δένδρα και την ευαισθησία απέναντι στο φυσικό περιβάλλον. Έκτοτε στη γιορτή του 24 Αυγούστου προσφέρουμε (και συνεχίζουμε μέχρι σήμερα), με τις ευλογίες του Σεβασμιωτάτου Μητροπολίτη μας κ. Νικόδημου, αρτοκλασία ...

«Εγώ ειμι η άμπελος η αληθινή και ο πατήρ μου ο γεωργός εστιν» ( Ιω. 15,1). Με την παρουσία του Χριστού στον κόσμο και την παράδοση της Θείας Ευχαριστίας προ του Θείου Πάθους Χριστιανισμός και Οίνος συμπορεύονται άρρηκτα. Ο Οίνος αποτελεί αναπόσπαστο μέρος των Τιμίων Δώρων αποτελώντας μετά τον καθαγιασμό το Τίμιο Αίμα που μεταλαμβάνουν οι πιστοί. Η Χερσόνησος του Άθω, ήταν από αρχαιοτάτων χρόνων, παρά την αγριότητα του τοπίου της, ένας ευλογημένος αμπελότοπος. Ο Όσιος Αθανάσιος ο Αθωνίτης συντάσσοντας τον καταστατικό χάρτη του Αγίου Όρους ορίζει πως κάθε μονή οφείλει να έχει τον δικό της αμπελώνα. Από τότε η οργανωμένη αμπελοκαλλιέργεια υπάρχει συνεχώς και αδιαλείπτως για πάνω από μία χιλιετία στο Άγιο Όρος, το Περιβόλι της Παναγιάς. Ποικιλίες αμπέλου, μικροκλίματα, ιδιαίτερες ...

Από την επί του όρους ομιλία του Κυρίου Οι Μακαρισμοί Πλήθος ανθρώπων ακολουθούσαν τον Κύριο για ν’ ακούσουν τα λόγια του, αλλά κι επειδή έλπιζαν σε κάποια θεραπεία. Για να τον ακούσουν καλύτερα, ο Ιησούς ανέβηκε σ’ ένα ύψωμα και δίδασκε από εκεί (Επί του όρους ομιλία). Τους έλεγε: «Μακάριοι (ευτυχισμένοι) είναι όσοι έχουν ταπεινό φρόνημα και μικρή ιδέα για τον εαυτό τους, γιατί σ’ αυτούς ανήκει η Βασιλεία των Ουρανών. Μακάριοι είναι εκείνοι που τώρα λυπούνται και πενθούν για τις αμαρτίες τους, γιατί αυτοί θα παρηγορηθούν από τον Θεό. Μακάριοι είναι όσοι είναι πράοι και συγκρατούν την οργή τους, γιατί αυτοί θα κληρονομήσουν τη γη. Μακάριοι είναι όσοι πεινούν και διψούν για δικαιοσύνη, γιατί θα χορτάσουν όταν έρθει η βασιλεία του Θεού. Μακάριοι είναι αυτοί που ...

Στις 24 του μηνός Αυγούστου, η Εκκλησία εορτάζει και τιμά την ιερή μνήμη του αγίου ιερομάρτυρα Κοσμά του Αιτωλού. Ο άγιος Κοσμάς είναι από τους αγίους της Εκκλησίας, που ονομάζονται Νεομάρτυρες και αναφάνηκαν στα χρόνια της τουρκοκρατίας. Οι Τούρκοι, μετά την άλωση της Κωνσταντινουπόλεως, είναι στην Ανατολή οι νέοι διώκτες της Εκκλησίας, και τότε πολλοί χριστιανοί, άνδρες και γυναίκες, για να μην αλλαξοπιστήσουν, προτίμησαν κι έδωκαν τη ζωή τους. Αυτοί είν’ εκείνοι, που με το παράδειγμα και τη θυσία τους, κράτησαν ζωντανή την ορθόδοξη πίστη των υπόδουλων χριστιανών της Ανατολής. Ο άγιος Κοσμάς γεννήθηκε το 1714 στο χωριό Μεγάλο Δένδρο της Αιτωλίας, γι’ αυτό και ονομάζεται Αιτωλός. Έμαθε τα πρώτα γράμματα του καιρού εκείνου κι ύστερα έκαμε το δάσκαλο στα χωριά ...

Μετά την καταστολή της Ορλωφικής επαναστάσεως ο Ισαπόστολος Κοσμάς προσκαλείται από το Πατριαρχείον της Κωνσταντινουπόλεως, για να αναλάβη μία μεγάλη υπηρεσία προς την τουρκοκρατούμενη και δεινοπαθήσασα από το αιματοκύλισμα χώρα. Ο Μουσταφά Γ', φοβούμενος καινούργια επανάστασι, απεφάσισε την μεταφορά όλου του Ελληνικού στοιχείου από την Ελληνική χερσόνησο στα βάθη της Ασίας και την μεταφορά από εκεί Τουρκικών φυλών, για να κατοικήσουν σ’ αυτή. Διεμαρτυρήθη το Πατριαρχείο για τον λόγο αυτόν και επί πλέον έστειλε τον Άγιο Κοσμά να μεσολαβήση για την ματαίωσι της ολεθρίου αυτής αποφάσεως για τον Ελληνισμό. Εγνώριζαν στο Πατριαρχείο ότι ο Διδάχος έχαιρε εκτιμήσεως εκ μέρους του Σουλτάνου, ένεκα των αγαθών πληροφοριών που είχε από τους αγάδες γι’ αυτόν. Πηγή:agioskosmasoaitolos.wordpress.com Πράγματι, ο Άγιος Κοσμάς υπεσχέθη στο Σουλτάνο ότι ...

Δύο σεβαστοί Γέροντες Λαυριώτες την Τρίτη της Διακαινησίμου περί το έτος 1982, μετά την Λιτανεία και τον Αγιασμό που γίνεται στον αρσανά της Μεγίστης Λαύρας, πήραν το καραβάκι της Ιερισσού και απεβιβάσθησαν στον Αρσανά της Μονής Χιλανδαρίου, και κατόπιν με τρακτέρ που έστειλεν η Μονή μετεφέρθησαν σ’ αυτήν για προσκυνηματικούς λόγους, όπου και διανυκτέρευσαν. Ο μακαριστός σήμερα Ηγούμενος και τότε Ιερομόναχος Παΐσιος, κατά πολύ ενάρετος και αγωνιστής, τους φιλοξένησε φιλοφρόνως με πολλή αγάπη. Το βράδυ εκεί πού συζητούσαν, τα έφερεν ο λόγος και για τους αφανείς ασκητές του Αγίου Όρους, πού τους τελευταίους καιρούς σχεδόν εξέλειπαν. Λαβών αφορμήν εκ της συζητήσεως ο Σέρβος Ιερομόναχος είπε στους Λαυριώτες Πατέρες τήν έξης διήγηση: «Όταν ήταν νεώτερος, μαζί με έναν άλλο Μοναχό εστάλησαν υπό της Μονής στα σύνορο ...

Ο παρατηρητής αστρονόμος, χαράκτης και οδοιπόρος, αναλύοντας το φως των αστεριών «Γιατί να ψάχνω αριθμούς και λάμψεις στα σκοτάδια; Φαινόμενες λαμπρότητες, αστέρων τις ροές; Μήπως κι εγώ θαμπώθηκα από ειδικές εντάσεις, τις αστρικές εκλάμψεις, φλεγόμενες μορφές;» Αυτές οι προτάσεις κρύβουν ένα ολόκληρο και πολύ ενδιαφέρον κεφάλαιο της Αστροφυσικής με τις «Φωτεινότητες, τις φαινόμενες λαμπρότητες και τα φαινόμενα μεγέθη των αστεριών». Απλώς, για να δώσουμε μια ιδέα για μερικές από τις πιο θεμελιώδεις έννοιες της Αστροφυσικής, ας δούμε πώς ακριβώς ορίζονται. Χαράκτης και οδοιπόρος Μετρώντας τα άστρα του ουρανού χαράκτης κι οδοιπόρος το ασημένιο φως τους, με μάγεψε μεμιάς. Γιατί να ψάχνω αριθμούς και λάμψεις στα σκοτάδια; Φαινόμενες λαμπρότητες, αστέρων τις ροές; Μήπως κι εγώ θαμπώθηκα από ειδικές εντάσεις, τις αστρικές εκλάμψεις φλεγόμενες μορφές; ...

Στην ακολουθία του Όρθρου ψάλεται ο Πολυέλαιος «Δούλοι Κύριον» έρρυθμα για να ταιριάζει η ψαλμωδία με την κίνηση του κατζίου,του θυμιατού με το οποίο θυμιάζουν οι μοναχοί που έχουν το διακόνημα του εκκλησιαστικού. Το κατζίο είναι φορητό και χρησιμοποιείται στις λατρευτικές συνάξεις εντός του ναού όταν ψάλλονται ύμνοι από την Παλαιά Διαθήκη ή αναγινώσκονται οι Μεγάλες Ώρες. Είναι μεταλλικό με μακριά χειρολαβή και κουδούνια, τα οποία συμβολίζουν τα βήματα του Θεού στον Παράδεισο και προτρέπουν τους μοναχούς σε εγρήγορση :'''Και άκουσαν τη φωνή του Κυρίου του Θεού, να περπατάει στον παράδεισο προς το δειλινό'' (Παλαιά Διαθήκη Γένεση Κεφ. 3, Στίχος 8.. Όταν οι εκκλησιαστικοί θυμιάζουν με το κατζίο φέρουν στον ώμο τους ένα τετράγωνο ύφασμα που λέγεται ''αήρ'' ΄ συνήθως είναι χρυσοποίκιλτο και ...

Εκατοντάδες ήταν και φέτος οι πιστοί που συνέρρευσαν στο Προσκύνημα της Παναγίας Καθολικής στη Κρεμαστή Ρόδου, προκειμένου να τιμήσουν την Απόδοση της Εορτής της Κοίμησης της Θεοτόκου. Σήμερα ανήμερα της εορτής, Σαββάτο 23η Αυγούστου 2014, τελέστηκε λαμπρό συλλείτουργο στο οποίο συλλειτόυργησαν ο Σεβασμιώτατος Μητροπολίτης Ρόδου κ Κύριλλος και ο Μητροπολίτης Άκκρας κ. Σάββας συμπαραστατούμενοι από κληρικούς της Ρόδου και Άκκρας. Μετα το πέρας της Θείας Λειτουργίας ο Σεβασμιώτατος Μητροπολίτης Ρόδου κ. Κύριλλος απήνειμε το οφίκιον του Αρχιμανδρίτου στον π. Ευλόγιο, ο οποίος διακονεί στην Μητρόπολη Άκκρας στην Αφρική και βρέθηκε στην πανήγυρη συνοδεύοντας τον Μητροπολίτη Άκκρας κ. Σάββα. Πρόκειται για μια κίνηση συμβολική που τονίζει τις οικουμενικές διαστάσεις τις Εκκλησίας, την ιεραποστολική της αποστολή και την καθολική τιμή της Θεοτόκου. Μετά το ...